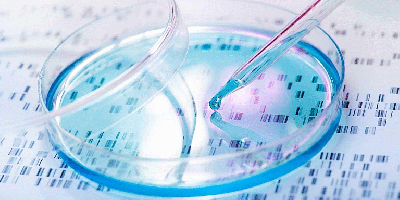

Kategorija: Zinātne un Reliģija
79 Posts


… iz laika rēķinu vēstures Nr. A

Fjodors Dostojevskis

JA KĀDS RADĪTS DARBAM …

Vecā gada, Jaunā gada ticējumi

APBRĪNOJAMI! . . .

ARĪ VECUMS IR RELATĪVS JĒDZIENS

VIŅI JAU TĀPAT ZINA…

Precīzas pazīmes

MUĻĶĪBA SKATĀS IEKŠĀ

PIETIEK TIKAI PASKATĪTIES

BET ATZĪSTIET ARĪ JŪS…

PIRMĀ BEZSĀPJU OPERĀCIJA
PĀRĀK DUMJŠ
